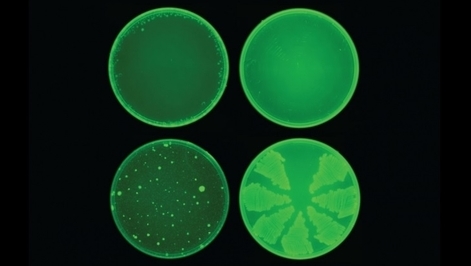

Ben je geïnteresseerd in de wereld van wetenschap & technologie en wil je hier graag meer over lezen? Word dan lid van KIJK!
Een antibioticum gevonden door een slim algoritme blijkt een krachtige killer. Wordt kunstmatige intelligentie dé troef in onze strijd tegen antibioticaresistentie?
Het was Alexander Fleming die aan het begin van de twintigste eeuw bij toeval het eerste antibioticum ontdekte. Terwijl hij in zijn lab onderzoek deed naar stafylokokken, trof hij in een van zijn petrischaaltjes leegtes aan tussen de bacteriekoloniën. Hier vond Fleming de schimmel Penicillium chrysogenum, die een bacteriedodend stofje achterliet: penicilline. Zijn ontdekking markeerde het begin van een scala aan nieuwe antibiotica.
Helaas raakt het potje van ontdekkingen langzaam op, terwijl de vijand zich steeds beter bewapent tegen bestaande medicatie. Maar gelukkig is er goed nieuws. Onlangs hebben wetenschappers van MIT en Harvard kunstmatige intelligentie ingezet om een nieuw antibioticum op te sporen. Het nieuwe middel, halicin, zou “een van de meest krachtige antibiotica ooit ontdekt” zijn, aldus het team.
Lees ook:
Genadeloos
De onderzoekers leerden hun A.I.-systeem om structuren van moleculen met antibacteriële activiteit tegen E. coli te herkennen. Hiervoor gebruikten ze een database van 2500 bekende moleculen, waaronder goedgekeurde medicatie en achthonderd natuurlijke stoffen. Vervolgens liet het team hun slimme systeem los op een nieuwe database van zesduizend moleculen. Hieruit rolde een kandidaat-molecuul met wellicht sterke antibacteriële eigenschappen: halicin – ooit ontwikkeld als diabetesmedicijn.
Dit molecuul, vernoemd naar de intelligente boordcomputer ‘HAL’ in de film 2001: A Space Odyssey, werd vervolgens uitvoerig getest in het lab. In petrischaaltjes ging het middel de strijd aan met diverse bacterieculturen, waaronder de resistente Clostridium difficile en Mycobacterium tuberculosis. Hier sloeg halicin genadeloos toe. Alleen de resistente Pseudomonas aeruginosa, die longinfecties veroorzaakt, wist te ontsnappen aan de bacterieverslinder.
Een logische vervolgstap was om halicin op de proef te stellen in een diermodel. De wetenschappers infecteerden daarom twee muizensoorten met Acinetobacter baumannii, een multiresistente bacterie die vaak toeslaat in het ziekenhuis. Ook hier bleek het medicijn effectief: de dieren waren binnen een etmaal volledig infectievrij.
ATP tekort
Natuurlijk ging het team ook op zoek naar het mogelijke werkingsmechanisme van de bacteriekiller. Zo zou halicin het elektrochemische gradiënt verstoren op de buitenste membraan van de bacterie. Dit gradiënt is nodig om ATP, een energiedragend molecuul cruciaal voor alle processen in de cel, te produceren. Een gebrek aan ATP betekent al gauw het einde van de bacterie.
De onderzoekers verwachten dat bacteriën ook niet snel resistent worden tegen dit middel. De bacterie zou dan zijn buitenkant zodanig moeten aanpassen dat het niet meer herkend wordt. En dat zijn evolutionair gezien moeilijk te verkrijgen mutaties.
In de toekomst hoopt het team, in samenwerking met een farmaceutisch bedrijf, halicin te ontwikkelen dat geschikt is voor het testen in mensen. Daarnaast plannen de wetenschappers om nog eens tien andere potentiële moleculen uitgebreid te onderzoeken. Die werden namelijk gevonden tijdens het screenen van 100 miljoen moleculen in een andere gigantische database (van totaal 1.5 miljard moleculen). Zo biedt kunstmatige intelligentie ons weer een nieuwe kans in onze eeuwige strijd met akelige ziekteverwekkers.
Beeld: Collins Lab at MIT